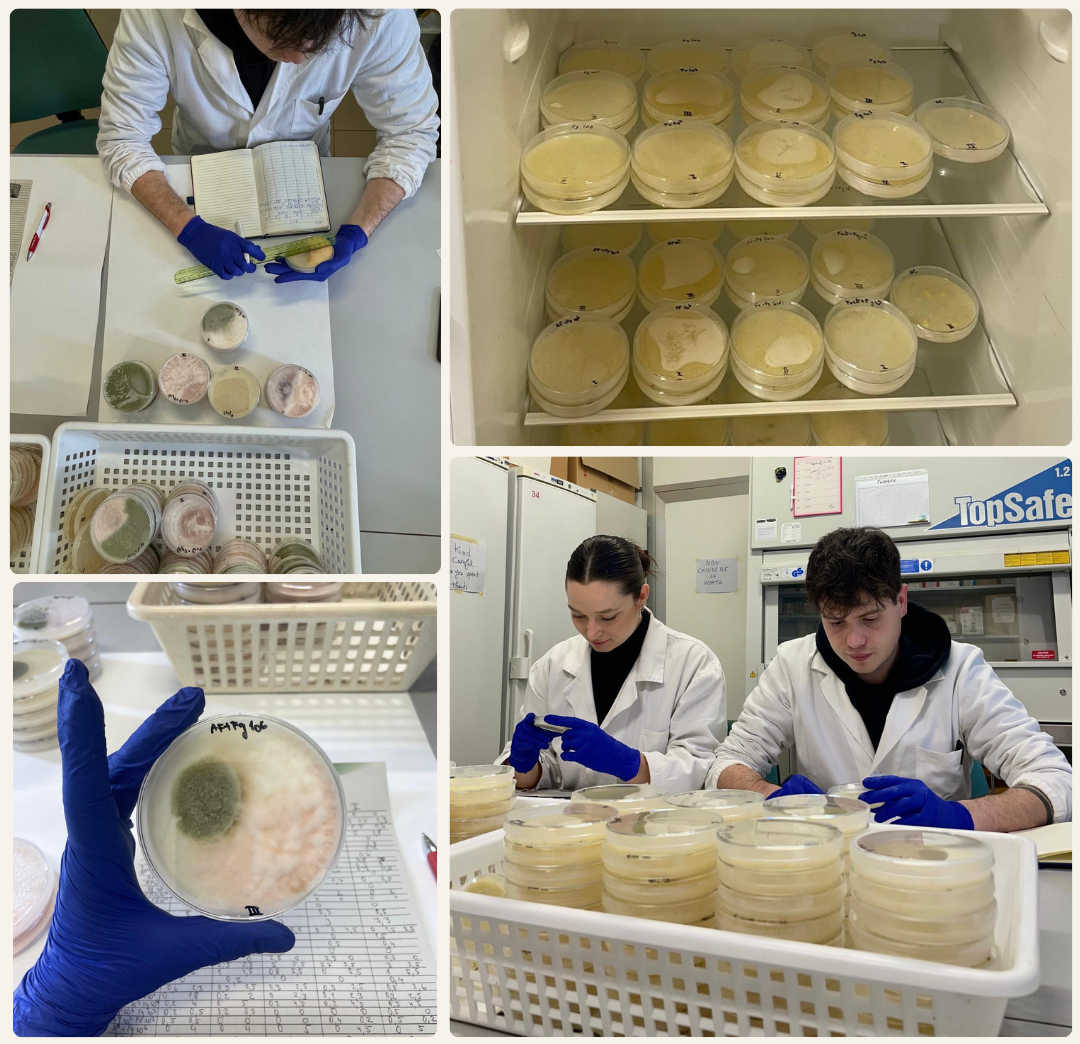
WP6 update: new ecological data to support more robust and biologically grounded predictive models

Building the first AI-driven mycotoxin management platform to address the impact of climate change on food safety and human health.
A 4-year European project tackling mycotoxins and food safety through innovation and predictive science.
Project Overview.Project overview
Context
Climate change (CC) significantly increases food safety risks by creating conditions, such as higher temperatures or changes in rainfall patterns, that favour the proliferation of pathogens and the occurrence of contaminants in the food supply chain, and by introducing unfamiliar or new hazards.
The MYMATCH project aims to understand and address these challenges, by predicting and mitigating the risks associated with mycotoxins (MY) in our food, ensuring a safer food supply for all.

Main objective
The main outcome of the project will be the creation of the MYMATCH AI mycotoxin management platform, which will provide all food system stakeholders (agri-food researchers, industry, policymakers, farmers and consumers) with rapid, tailored predictions; descriptive information on contamination risk/levels; and practical, economically sound suggestions for intervention. This will help them make informed decisions and take effective threat-mitigation and adaptation measures, in both the short and long term.

Concept
– MYMATCH will address knowledge gaps on the occurrence of mycotoxigenic fungi in European food systems through sampling in 115 maize, 105 wheat and 65 tomato fields in 7 countries (Italy, Hungary, Serbia, England, Portugal, Norway, Spain); identification and characterization of fungi belonging to 3 fungal genera (Aspergillus, Fusarium, and Alternaria) and main related mycotoxins (aflatoxins (AF), fumonisins (FUM), trichothecenes (TCT), zearalenones (ZEN), Alternaria toxins). (O1)
– This dataset, together with data from the existing literature, will enable the improvement and extension of predictive models for the risk of MY occurrence based on accurate climate change scenarios, provided by MYMATCH’s CC Scenario Builder. (O2&O3)
– MYMATCH will deliver the following ready-to-use tools to support policymakers, food industries, and producers making appropriate decisions: a fungus and MY occurrence Risk Prediction Module, a Decision-Support System (DSS), and the MYMATCH AI Mycotoxin Platform. (O4)
– MYMATCH will develop guidelines for MY mitigation and adaptation measures for the food systems adjusted to future CC conditions, to provide appropriate advice to practitioners (farmers, technicians, industry). (O5)
– Policy recommendations will be addressed to local and EU policymakers. (O6)
– MYMATCH tools and methods will be easily extendable to other contaminant issues.
– The whole project will rely on a strong multi-actor partnership with relevant stakeholders and end-users, to ensure that the development of the project is aligned with their inputs and needs.

Latest updates
Mini-symposium on toxin-producing fungi at Ghent University

Analysing the impact of climate change related environmental factors on fungal ecology and physiology

WP6 update: new ecological data to support more robust and biologically grounded predictive models